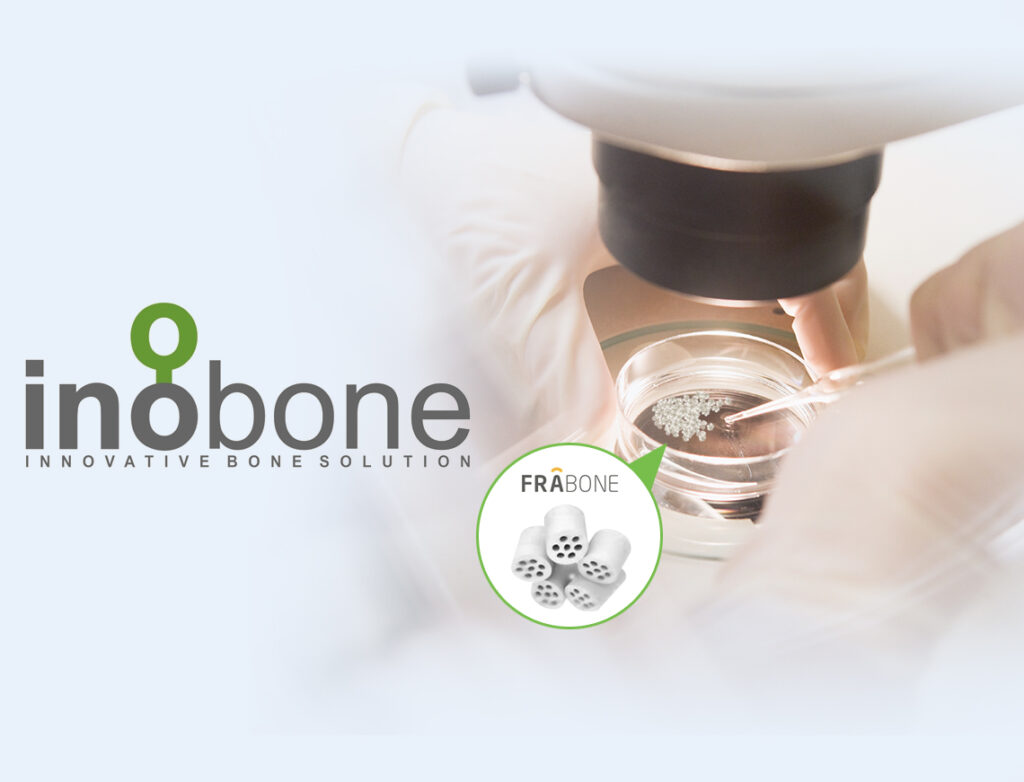
visual1

- +51 998 802 519
- E-mail: ventas@iberoproducts.com
- Calle Los Suspiros del Moro Nro. 184, La Molina
Menu
Edit
Nosotros
Somos una empresa formada por expertos y profesionales del sector cuyo objetivo es proporcionar a los profesionales del sector el mejor material para dentistas y para clínica dental con una excelente relación calidad-precio.
Información Empresa
- Calle Los Suspiros del Moro Nro. 184, La Molina, Lima
- +51 998 802 519
- ventas@iberoproducts.com
- Días Semana: 09.00 a 18.00, Domingo: Cerrado